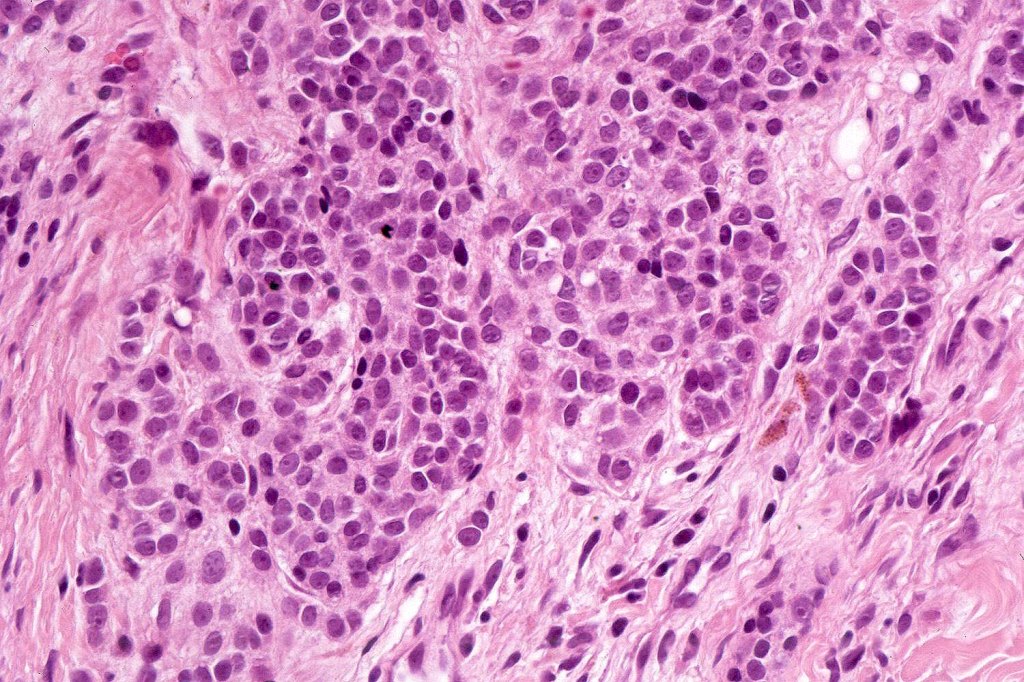
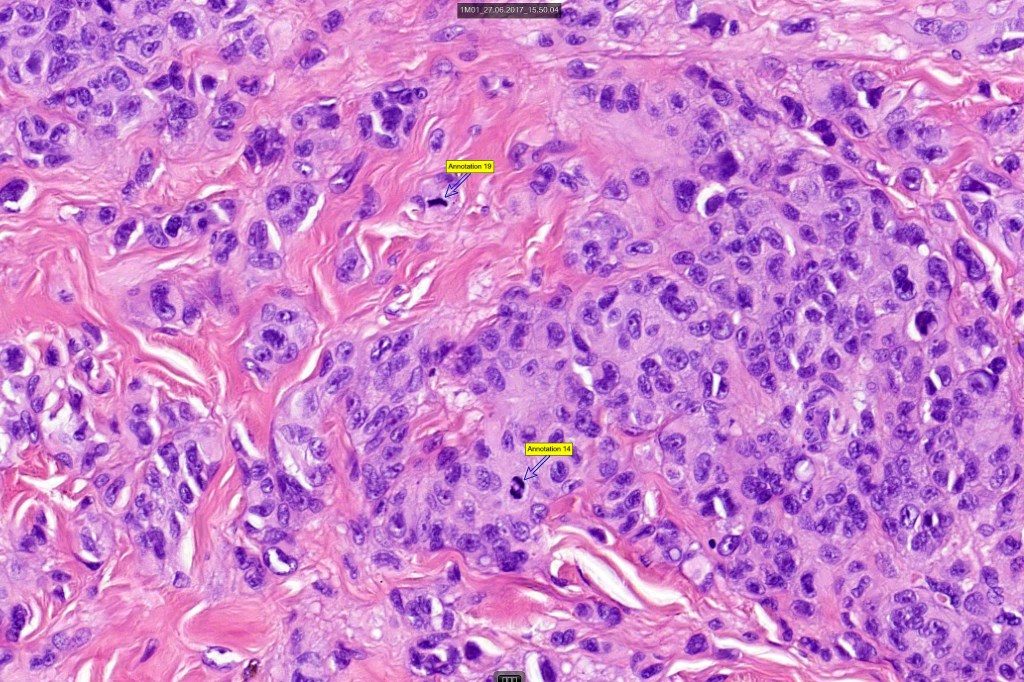
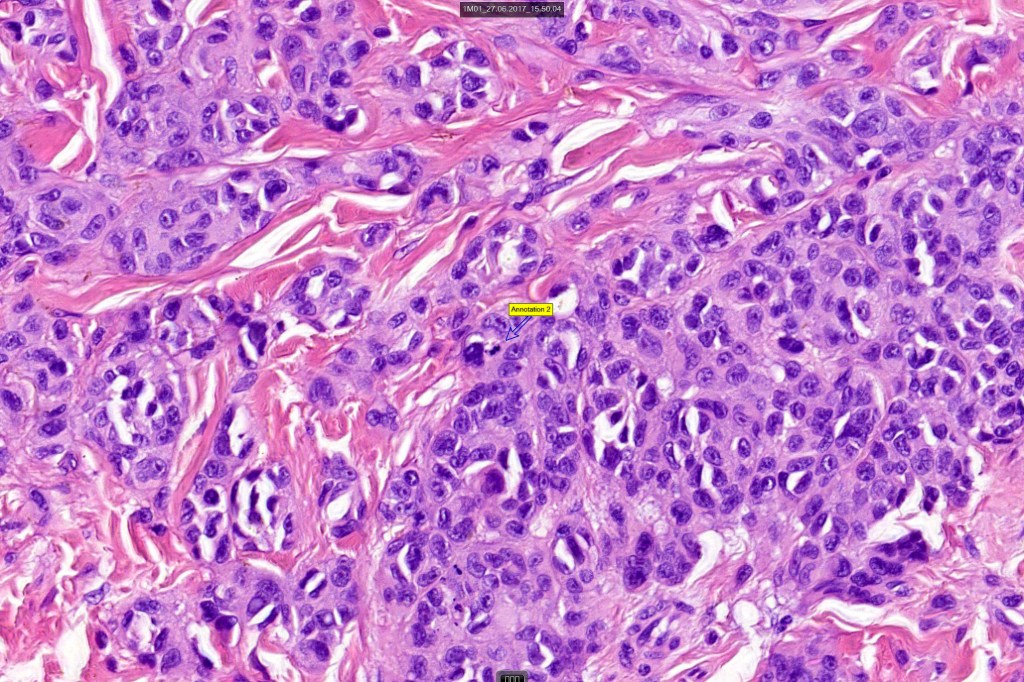

Definition & clinical features
•A melanoma which you diagnosed as nevus and wish that you hadn’t!; a melanoma that closely mimics especially on scanning magnification
•The correct diagnosis often comes to light when it recurs or metastasizes
•Results from insufficient time being spend on a nevoid lesion
•Behaves no differently than any other melanoma
•Everyone has fallen into this trap!! (if you think you haven’t, you have or you certainly will)!!*
•Bad news for the patient and you!
•Medical malpractice litigation is increasing at an alarming rate both in the United States and abroad. In a recent publication, over 50% of physicians had experienced a malpractice claim during their career (Crowson A N (2006) Modern Pathology;19:S148-S154 n
•Nevoid melanoma is one of the more common misdiagnoses in dermatopathology
•Verrucous or nodular
•Equal sex incidence
•Any age (16-89)
•Verrucous variant, head, neck & limbs
•Nodular variant, limbs & trunk
•Verrucous variants similar to other forms of melanoma
•Although nodular variants have been said to have a better prognosis, this requires further study in larger series
Histological features
•Verrucous or dome-shaped, at low power, the lesion looks like a nevus
•Minimal or no junctional component
•Expansile nodules or diffuse
•Compression of connective tissue
•Stretched & elongated rete ridges in verrucous variants
•Mimics type-A cells, (lesions which mimic type B nevus cells are often classified as small cell melanoma, this is important as the differential diagnosis is very different- see separate blog)
•Subtle or not so subtle impaired maturation with depth (sometimes this is evident at scanning magnification)
•Subtle nucleolar prominence
•Subtle pleomorphism
•Mitoses invariable including often in the deep aspect
•NRAS and BRAF mutations described in a small number of cases
Immunohistochemistry
•S100 & SOX10 are useful to highlight impaired maturation
•HMB45 expressed throughout
•Cyclin D1 & Ki67 often show marked expression
•P53 may be over-expressed
PRAME +ve in the very few cases that I have encountered using this antibody

Leave a comment